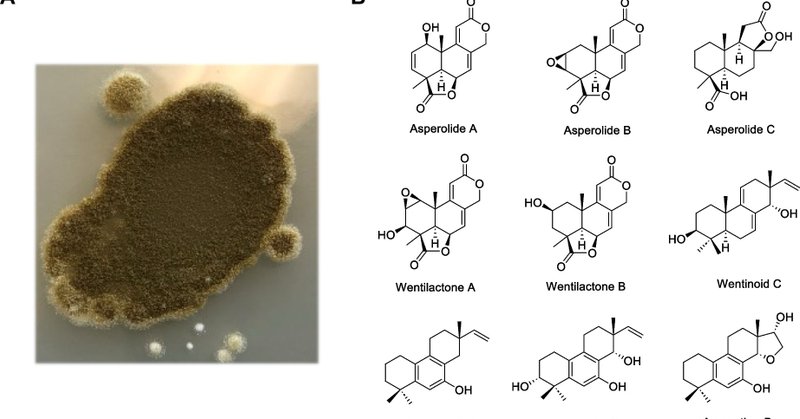
Tweet card summary image

Middle Author Bioinformatics
@midauthorbio
Followers
298
Following
18
Media
3
Statuses
147
Your friendly neighborhood bioinformaticians :) Learn more about the company here: https://t.co/mKJMDNLhBe Check out our free bioinformatics web app: omix.midauthorb
Phoenix, AZ
Joined July 2021
Plasmodium falciparum is the protozoan parasite behind the most severe form of malaria, transmitted by Anopheles mosquitoes. If you want to see where P. falciparum sits in the tree of life, you can now do so easily with our microbial omics web app: https://t.co/1M6zEatvxP in
1
1
1
3. Open the .tre file with FigTree or similar software for viewing phylo trees/newick files https://t.co/YxsAnC3VZU
1
0
0
Bioinformatics without the command line? Yes please. We just launched a free app where non-comp bio folks can run bioinformatics software like SprayNPray, Megahit, Bakta, and more, via simple GUIs. Get your FASTAs ready! https://t.co/1M6zEatvxP
omix.midauthorbio.com
A suite of bioinformatics tools for microbial genome and metagenome analysis.
0
3
11
Characteristics of psychrophilic bacterial communities and associated metabolism pathways in different environments by a metagenomic analysis. https://t.co/uidXwDKJsV
0
0
1
Whole-genome sequences of fermentative and spoilage-associated lactic acid bacteria, <i>Lysinibacillus capsici</i> and a <i>Serratia marcescens</i> isolated from commercial cucumber fermentations. https://t.co/8fjlG4SfQs
journals.asm.org
We document genome sequences of Bacilli and a Serratia marcensens isolated from commercial cucumber or sauerkraut fermentations between 1985 and 2015 to augment understanding of the genetics,...
0
0
3
Methylocystis borbori sp.nov., a novel methanotrophic bacterium from the sludge of a freshwater lake and its metabolic properties. https://t.co/n3egjYi83U
0
0
1
Statistical design approach enables optimised mechanical lysis for enhanced long-read soil metagenomics. https://t.co/gvo92TKsvX
nature.com
Scientific Reports - Statistical design approach enables optimised mechanical lysis for enhanced long-read soil metagenomics
0
0
1
Bioinformatics analysis of the Microsporidia sp. MB genome: a malaria transmission-blocking symbiont of the Anopheles arabiensis mosquito. https://t.co/qpChQheSuj
bmcgenomics.biomedcentral.com
Background The use of microsporidia as a disease-transmission-blocking tool has garnered significant attention. Microsporidia sp. MB, known for its ability to block malaria development in mosquitoes,...
0
0
1
De Novo Long-Read Genome Assembly and Annotation of the Mosquito Gut-dwelling Fungus, Smittium minutisporum. https://t.co/UDLLAJzGvu
academic.oup.com
Abstract. Mosquito guts host a variety of microbes, yet fungi are often overlooked. Smittium (Harpellales, Zoopagomycota) comprises numerous species that a
0
0
1
Corrosion of carbon steel by Pseudomonas stutzeri CQ-Z5 in simulated oilfield water. https://t.co/IdBOc197NE
0
1
1
The golden genome annotation of Ganoderma lingzhi reveals a more complex scenario of eukaryotic gene structure and transcription activity. https://t.co/FAspk5miU1
bmcbiol.biomedcentral.com
Background It is generally accepted that nuclear genes in eukaryotes are located independently on chromosomes and expressed in a monocistronic manner. However, accumulating evidence suggests a more...
0
1
1
PHI-base - the multi-species pathogen-host interaction database in 2025. https://t.co/BysTE8Gek3
academic.oup.com
Abstract. The Pathogen–Host Interactions Database (PHI-base) has, since 2005, provided manually curated genes from fungal, bacterial and protist pathogens
0
0
0
Genome sequence of potential psychobiotic <i>Lacticaseibacillus rhamnosus</i> A20T1A using long-read ONT technology. https://t.co/680mLpLaKw
journals.asm.org
In the last years, lactic acid bacteria (LAB) have been increasingly reported to produce neuroactive molecules, able to modulate mood and cognition in humans (psychobiotics) (1). The strain was...
0
0
0
Identification of a terpene synthase arsenal using long-read sequencing and genome assembly of Aspergillus wentii. https://t.co/Iq7GpzBoMh
link.springer.com
BMC Genomics - Fungi are talented producers of secondary metabolites with applications in the pharmaceutical and agrochemical sectors. Aspergillus wentii CBS 141173 has gathered research interest...
0
0
0
Precision Activity-Based α-Amylase Probes for Dissection and Annotation of Linear and Branched-Chain Starch-Degrading Enzymes. https://t.co/Ear6p8gP23
onlinelibrary.wiley.com
Activity-based probes were designed as a method to annotate substrate specificity of retaining α-amylases. Fluorescent probes were used in activity-based protein profiling experiments with pure...
0
0
0
Whole genome analysis of Stenotrophomonas geniculata MK2 and antagonism against Botrytis cinerea in strawberry. https://t.co/ywquHX81iU
link.springer.com
International Microbiology - A novel strain isolated from soil identified as Stenotrophomonas geniculata MK2 could control strawberries’ postharvest disease gray mold. An in vitro...
0
0
0
Bifidobacteriaceae diversity in the human microbiome from a large-scale genome-wide analysis. https://t.co/T3dMOXQVU1
0
0
0
Genome-wide identification of SSR markers from coding regions for endangered Argania spinosa L. skeels and construction of SSR database: AsSSRdb. https://t.co/MAFGy1fHpK
academic.oup.com
Abstract. Microsatellites [simple sequence repeats (SSRs)] are one of the most widely used sources of genetic markers, particularly prevalent in plants. De
0
0
0